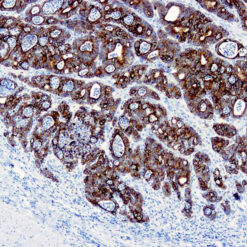
Formalin fixed paraffin embedded human human colon carcinoma stained with Cytokeratin 19 antibody

Claudin 18.2
Description
Claudins are protein family and represent tight cell junctions in epithelial cells. One of the important protein is Claudin18, which is located on the epithelial cell surface. The Mol. Weight of this antigen is 27.8kDa. In gastric epithelium, it participates in forming a paracellular barrier against hydrochloric acid. These are two different splice isoforms for CLDN18.1 and CLDN18.2 are mainly expressed in normal gastric and lung tissues. In particular, CLDN18.2 is a highly selective gastric lineage marker expressed in short lived differential cells but not in stem cell zone of stomach mucosa. A frequent CLDN18.2 alteration reported in different tumor types, including gastric, pancreaticobiliary, esophageal, Ovarian and non-small cell lung cancers. A higher prevalence of claudin18.2 positive gastric cancer, 38.4% of patients were deemed to have claudin18.2 positive tumors.
Additional information
| Catalog No. | RMAB116R, RMPD116R |
|---|---|
| Clone | DBRRM1.82 |
| Isotype | IgG, kappa |
| Immunogen | Recombinant human Claudin18.2protein fragment (around aa 1-100) |
| Species | Rabbit |
| Cellular Localization | cell membrane |
| Positive Control Tissue | Stomach |
| Pretreatment | EDTA Buffer pH 8.0 (Manual/ Montage) |
| Incubation & Temperature | 30 min @ RT |
| Intended Use | RUO |
| Detection System | PolyVue™ Plus – Two Step Detection System or Montage PolyVue Plus™ Auto Detection System for Montage 360 System or HighLighter core kit for HighLighter Staining System |
| Description/Type | FFPE, Rabbit Monoclonal Antibody |
| Format | Purified immunoglobulin |
DATASHEETS & SDS
DATASHEETS & SDS
| Download Datasheet |
REFERENCES
REFERENCES
- i) Mod Pathol 2021;34:710
- ii) Hum Pathol 2022;125:97
- iii) Hum Pathol 2023;138:62
- iv) Int J Cancer Biomed Res 2023;7:13
Reviews (0)
Only logged in customers who have purchased this product may leave a review.

Reviews
There are no reviews yet.